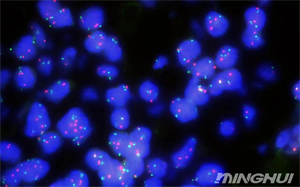
奥林巴斯BX53和荧光相机观察her-2荧光细胞4.jpg
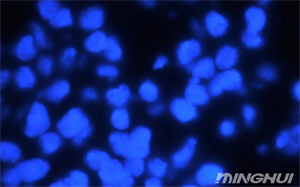
奥林巴斯BX53和荧光相机观察her-2荧光细胞6.jpg

服务实验教学、医学检验、生命科学研究与工业检测全领域
her-2是一种具有酪氨酸蛋白激酶活性的跨膜蛋白,也是表皮生长因子受体家族的一员。该基因位于人染色体17q12-21.3上,编码的her-2蛋白在正常细胞中处于非激活状态,低表达或不表达,参与细胞的正常生长、凋亡、增殖和分裂等功能。在肿瘤细胞中,her-2可能发生异常激活和变异,导致激酶活性增强或发生二聚化反应,进而激活肿瘤细胞增殖信号传导通路,促进肿瘤细胞的增殖、活化、侵袭和转移。

近日,广州明慧工程师了解到一家医疗公司需要观察her-2荧光细胞,推荐了奥林巴斯BX53荧光显微镜与荧光相机结合,实现对her-2荧光细胞的高灵敏度和特异性观察。

荧光显微镜下的her-2检测通常使用免疫组化(IHC)或荧光原位杂交(FISH)技术,能够准确地区分her-2阳性和阴性细胞,判断her-2的表达情况,以及定量评估和判断HER2基因是否扩增。
BX53支持多种荧光染料的观察,可以同时检测细胞表面或内部的不同标记物。在her-2检测中,可以同时观察her-2受体与其他相关蛋白或细胞器的共定位情况。

荧光相机通过测量荧光信号的强度和分布,可以准确地评估her-2受体的表达水平和分布情况,能够捕获并存储高质量的荧光图像用于后续的定量分析。
显微镜荧光相机MHC600的成像光谱从可见光扩展到近红外光,传感器接收弥散光,大幅降低传感器的噪声,在黑暗的环境下也可得到高亮度的照片,这使得它在弱光或荧光图像的拍摄与分析中表现出色,MHC600的高性能和广泛的适用性,具有较高的性价比,能够满足不同用户的需求。
奥林巴斯BX53显微镜与荧光相机结合在观察HER-2荧光细胞方面具有显著的优势和广泛的应用前景。
奥林巴斯BX53荧光显微镜搭配MHC600荧光相机,为HER-2荧光细胞检测提供高效解决方案。BX53支持多荧光染料观察,可精准定位HER-2受体与其他蛋白的共分布;MHC600相机凭借近红外成像与低噪技术,在弱光环境下仍能捕获高亮度荧光图像,实现HER-2表达水平的定量分析。该组合通过免疫组化或荧光原位杂交技术,可区分HER-2阳/阴性细胞,评估基因扩增状态,为肿瘤诊断提供高灵敏度、特异性的检测手段。

热线020-87096762

致电13418179239

